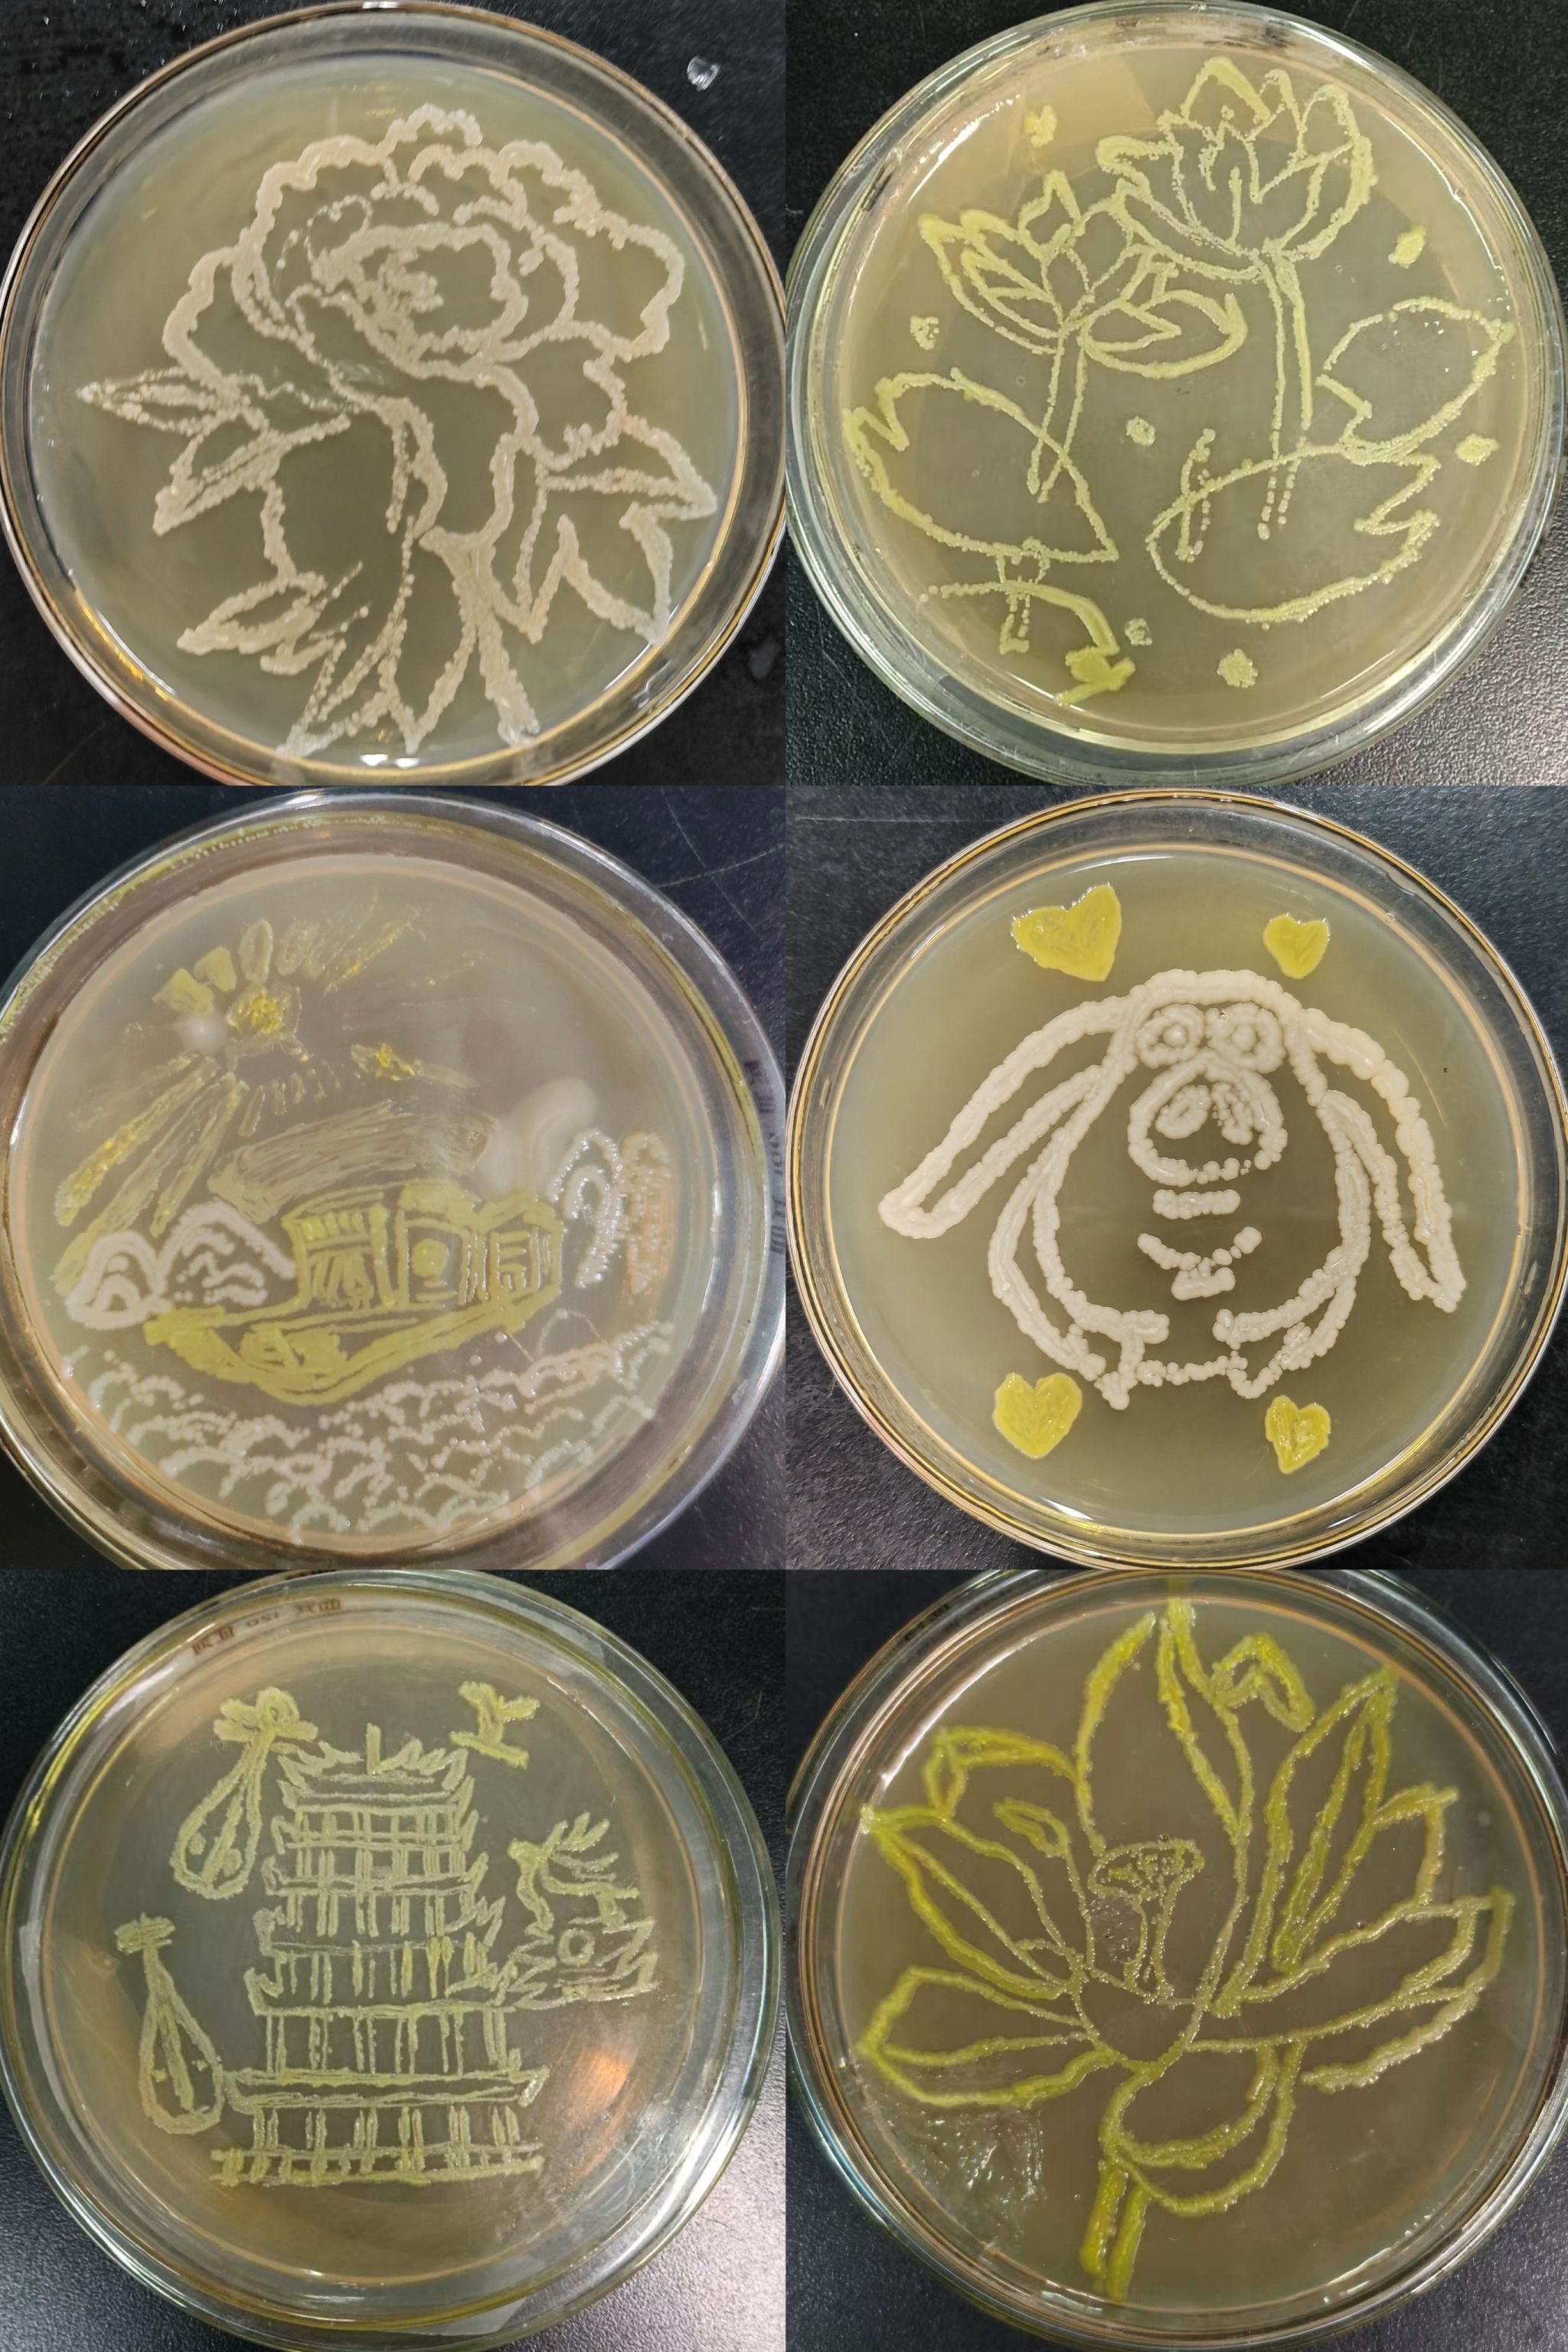

5月16日,365英國上市官方網(wǎng)站舉辦首屆大學(xué)生培養(yǎng)皿藝術(shù)設(shè)計(jì)大賽。本次大賽以“培養(yǎng)基上的藝術(shù)”為主題,吸引了來自學(xué)院各專業(yè)的近40名同學(xué)參賽。

大賽圍繞“創(chuàng)意性、科學(xué)性、原創(chuàng)性、安全性”四大核心要求展開。參賽選手需要利用微生物培養(yǎng)技術(shù)完成一件兼具科學(xué)原理與藝術(shù)美感的作品,作品不僅需體現(xiàn)微生物的生長(zhǎng)特性與形態(tài)結(jié)構(gòu),還需通過藝術(shù)設(shè)計(jì)展現(xiàn)獨(dú)特創(chuàng)意。選手們以微生物菌落為“畫布”,通過控制菌種分布與培養(yǎng)條件,繪制出特色建筑、美麗花卉、抽象圖案等作品,將菌落培養(yǎng)的技術(shù)符號(hào)化為藝術(shù)元素,賦予作品更深層的科學(xué)內(nèi)涵。評(píng)委從科學(xué)性、藝術(shù)性、創(chuàng)新性等多維度對(duì)作品進(jìn)行綜合評(píng)分,最終評(píng)選出了一、二、三等獎(jiǎng)共6名。
此次比賽通過將微生物培養(yǎng)技術(shù)與藝術(shù)創(chuàng)作相結(jié)合,激發(fā)了學(xué)生的創(chuàng)新思維與科研實(shí)踐能力,推動(dòng)生命科學(xué)與藝術(shù)設(shè)計(jì)的跨界融合。未來,學(xué)院將繼續(xù)搭建更多創(chuàng)新平臺(tái),助力學(xué)生成長(zhǎng)為兼具科學(xué)素養(yǎng)與人文情懷的復(fù)合型人才。